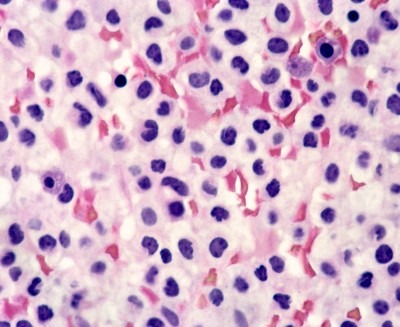
Лейкопения

Содержание
Лимфоциты – главная сила организма, они вступают в борьбу с любыми заболеваниями. Их количество напрямую связано с работой иммунитета. Если число Т-клеток повышено, то у человека фиксируется лимфоцитоз (значит, в организме идет воспалительный процесс). Если концентрация лимфоцитов в общем объеме циркулирующей крови ниже нужного уровня, то это состояние называется лимфопения.
Понижение количества лимфоцитов представляет угрозу для организма, поскольку он становится более уязвимым к различным инфекциям.
Значения нормы

При лимфопении уровень лимфоцитов меньше нижней границы (> 1000 и > 3000, у взрослых и детей соответственно).
В периферической крови три четверти (75%) занимают Т-лимфоциты, остальные 25% отданы В-лимфоцитам. При заболевании обычно наблюдается уменьшение уровня Т-клеток.
Лимфопения, или снижение уровня лимфоцитов в крови, вызывает обеспокоенность у врачей, так как это состояние может свидетельствовать о различных заболеваниях и нарушениях иммунной системы. Специалисты отмечают, что лимфопения может быть вызвана инфекциями, аутоиммунными заболеваниями, а также воздействием некоторых медикаментов и химиотерапии. Врачи подчеркивают важность своевременной диагностики и выявления причины этого состояния, так как оно может привести к повышенной восприимчивости к инфекциям и другим осложнениям. Лечение лимфопении зависит от основного заболевания и может включать как медикаментозную терапию, так и изменение образа жизни. Важно, чтобы пациенты обращались за медицинской помощью при первых признаках ухудшения здоровья, чтобы избежать серьезных последствий.

Разновидности болезни
- Врожденная – болезнь передается от матери малышу. Ребенок получает ее, находясь в утробе.
- Приобретенная форма – такое заболевание возникает после рождения. Развитие болезни может быть вызвано рядом причин.
- Абсолютная – состояние, при котором общий уровень лимфоцитов в крови ниже нормы. Может встречаться при лейкозе, лейкоцитозе, хронических заболеваниях печени и т.п.
- Относительная форма представляет собой состояние, когда общее количество лимфоцитов в лейкоцитарной формуле понижено, но их уровень является нормальным для крови здорового человека. В этом случае происходят нарушения в лимфатической системе, вследствие чего лимфоциты быстро гибнут. Встречается при заболеваниях, которые носят инфекционный или хронический характер.
Код по МКБ-10
D72.8 – другие уточненные нарушения белых кровяных клеток. В эту группу помимо лимфопении входят: лимфоцитоз, моноцитоз, плазмоцитоз, лейкоцитоз, лейкомоидные реакции.
Наглядно про нарушения белых клеток крови и лейкоцитоз можно посмотреть в видео ниже
Лимфопения — это состояние, при котором наблюдается снижение уровня лимфоцитов в крови. Многие люди, услышав этот термин, начинают беспокоиться о своем здоровье. В социальных сетях и форумах часто обсуждаются симптомы и причины лимфопении. Некоторые делятся личным опытом, рассказывая о том, как это состояние повлияло на их жизнь. Многие отмечают, что у них возникали частые инфекции и усталость, что заставляло их обращаться к врачам.
Специалисты подчеркивают важность диагностики и выявления первопричины лимфопении, так как это может быть связано с различными заболеваниями или воздействием лекарств. Люди также обсуждают методы повышения иммунитета и укрепления здоровья, включая правильное питание и физическую активность. Важно помнить, что при возникновении симптомов стоит обратиться к врачу для получения квалифицированной помощи и рекомендаций.

Причины заболевания
В случае врожденной формы болезни к основным причинам возникновения относятся следующие:
- врожденные заболевания иммунодефицитного характера,
- болезни, при которых нарушается выработка лимфоцитов,
- синдром Вискотта-Олдрича,
- иммунодефицит при тимоме.
Приобретенная лимфопения встречается чаще. Спектр болезней, которые вызывают это заболевание, шире. Главные причины приобретенной лимфопении:
- недостаток белка в рационе, употребление алкоголя,
- заболевания инфекционного характера, которые разрушают Т-клетки: синдром приобретенного иммунодефицита, туберкулез, гепатит, сепсис,
- повреждение структуры тимуса,
- нарушения в функционировании лимфоузлов,
- ультрафиолетовое облучение и длительное применение псоралена (обычно используется при лечении псориаза),
- цитотоксическая химиотерапия,
- лучевая терапия,
- некоторые аутоиммунные заболевания (ревматоидный артрит, СКВ, энтеропатия, апластическая анемия),
Другие причины возникновения лимфопении (временного характера) – беременность и длительное пребывание в стрессовых ситуациях. Разрушение Т-клеток также может быть вызвано применением глюкокортикоидов и введением антилимфоцитарного иммуноглобулина.
Симптомы болезни
В большинстве случаев заболевание протекает без симптомов. Лимфопения обнаруживает себя случайно, после сдачи общего анализа крови. К основным признакам можно отнести следующие симптомы:
- отсутствие (возможно уменьшение) миндалин и лимфоузлов,
- заболевания кожи, включающие в себя экзему, пиодермию, алопецию,
- зачастую больные лимфопенией подвержены инфекционным заболеваниям – ветряной оспе, краснухе.

Механизмы развития болезни
В случае диагностирования лимфопении врач должен определить, в результате каких процессов появилось данное заболевание. Это позволит назначить верное лечение. Существует четыре механизма, по которым может развиваться лимфопения:
- нарушения в развитии лимфоцитов – Т-клетки образуются в нормальном количестве, но они не могут «повзрослеть» вследствие какой-либо причины,
- образование и развитие лимфоцитов соответствует норме, но Т-клетки ускоренно разрушаются,
- лимфоциты не образовываются в нужном количестве, поскольку какие-либо факторы подавляют этот процесс.
В данных случаях у человека формируется абсолютная форма болезни. Содержание лимфоцитов в крови будет меньше 1000 на 1 микролитр.
Четвертый механизм формирования болезни заключается в том, что у человека вырабатывается нормальное количество лимфоцитов. Но в результате инфекционных болезней общее количество лейкоцитов повышается, а число лимфоцитов в лейкоцитарной формуле относительно остальных клеток меньше. Но фактически Т-клеток столько, сколько нужно здоровому организму. В этом случае формируется относительная форма лимфопении.
Лейкопения и лимфопения
Лейкопения представляет собой понижение общего числа лейкоцитов в крови, что делает организм уязвимым ко всем внешним агентам.
В крови больного может быть понижен или повышен определенный вид лейкоцитов. Например, при сокращении числа лимфоцитов речь идет о лимфопения. Если повышен уровень моноцитов, то у больного фиксируется моноцитоз.
Прогноз
Если лимфопению у взрослых и детей не лечить, то возможны неутешительные последствия. По сути, заболевание представляет собой дефицит иммунитета. На его фоне могут успешно развиваться онкологические опухоли, повышается риск аутоиммунных заболеваний и оппортунистических инфекций. В случае выявления лимфопении следует выполнить диагностические тесты и анализ субпопуляций лимфоцитов.
Лечение

Если болезнь носит приобретенный характер, то необходимо выяснить причину ее появления. Болезнь исчезает после устранения главного фактора, способствующего ее возникновению.
При хронической лимфопении у взрослых проводится длительный курс иммуноглобулинотерапии. Он поможет устранить заболевание и предотвратить рецидивирующие инфекции. Иммуноглобулины G помогают восстановить нормальный уровень лимфоцитов в крови. Прекращать терапию следует только в случаях угрозы жизни больному – развитие артериальной гипотонии или при сильных аллергических реакций на препарат.
При врожденном заболевании необходимо трансплантировать гемопоэтические стволовые клетки. Эта процедура успешна при врожденном иммунодефиците. Данный метод применим и к детям.
Если наблюдается лимфопения у детей, то стоит выяснить причину ее возникновения. Зачастую она встречается на фоне инфекционных заболеваний. После устранения инфекции лимфопения проходит, количество лимфоцитов в крови нормализуется.
Профилактика
Предотвратить врожденную лимфопению невозможно.

- употребление полезной пищи, содержащей необходимое количество белка,
- отказ от алкоголя,
- ведение здорового образа жизни,
- профилактика инфекционных заболеваний, которые вызывают лимфопению (СПИД, туберкулез),
- избегание стрессовых ситуаций.
Вопрос-ответ
Что такое лимфопения и как она проявляется?
Лимфопения — это состояние, характеризующееся снижением уровня лимфоцитов в крови ниже нормальных значений. Она может проявляться различными симптомами, такими как частые инфекции, усталость, увеличение лимфатических узлов и другие признаки ослабленного иммунитета.
Какие причины могут привести к лимфопении?
Лимфопения может быть вызвана различными факторами, включая вирусные инфекции, аутоиммунные заболевания, некоторые виды рака, а также побочные эффекты от химиотерапии или радиотерапии. Также она может возникать из-за недостатка питательных веществ, таких как витамин B12 или фолиевая кислота.
Как лечится лимфопения?
Лечение лимфопении зависит от ее причины. В некоторых случаях достаточно устранить основное заболевание или фактор, вызывающий снижение лимфоцитов. В других случаях может потребоваться иммунотерапия или применение препаратов, способствующих повышению уровня лимфоцитов. Важно проконсультироваться с врачом для назначения индивидуального подхода к лечению.
Советы
СОВЕТ №1
Обратитесь к врачу для диагностики. Лимфопения может быть симптомом различных заболеваний, поэтому важно пройти медицинское обследование, чтобы определить причину снижения уровня лимфоцитов в крови.
СОВЕТ №2
Следите за своим питанием. Убедитесь, что ваш рацион богат витаминами и минералами, особенно витаминами группы B, C и D, а также цинком и железом, которые поддерживают иммунную систему и могут помочь в восстановлении уровня лимфоцитов.
СОВЕТ №3
Избегайте стрессов и переутомления. Хронический стресс и недостаток сна могут негативно влиять на иммунную систему. Практикуйте методы релаксации, такие как медитация или йога, и старайтесь соблюдать режим сна.
СОВЕТ №4
Регулярно занимайтесь физической активностью. Умеренные физические нагрузки способствуют улучшению кровообращения и укреплению иммунной системы, что может помочь в повышении уровня лимфоцитов.

